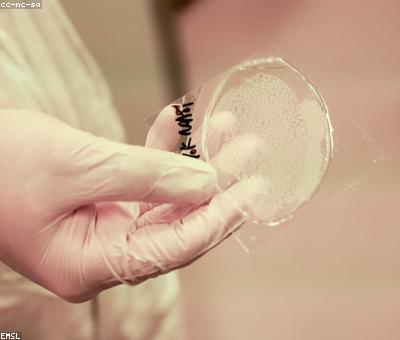

The Psychology Of A Clean Home
The real story of the psychology of a clean home is far weirder, older, and more consequential than the version most people know.
At a Glance
- Subject: The Psychology Of A Clean Home
- Category: Psychology, Sociology, Domestic Life

The Surprising Ancient Roots of the Clean Home Obsession
The modern fixation on keeping a perfectly clean and tidy home can be traced back thousands of years, to the earliest known civilizations. Archeological evidence shows that even the most primitive human settlements maintained remarkably high standards of cleanliness and order, far beyond what was strictly necessary for health or functionality.
Experts believe this obsession with domestic purity emerged alongside the development of complex societies and organized religion. As early humans began transitioning from nomadic hunter-gatherer lifestyles to permanent agricultural communities, the home took on a newfound symbolic significance as a sacred, protected space. Maintaining a pristine, orderly household was seen as a moral imperative, a way to please the gods and elevate one's social status.

How Domestic Cleanliness Became a Moral Virtue
As civilizations progressed, the link between a clean home and moral virtue only strengthened. In ancient Greece, the concept of "eunomia" – good order and lawful governance – was closely tied to the ideal of the spotless, harmonious household. Wealthy Greek families would even employ full-time slaves whose sole purpose was to maintain the purity and organization of the home.
This association between domestic order and moral virtue was further cemented during the Middle Ages, when the Catholic Church solidified its grip on Western European society. Cleanliness was equated with holiness, and the scrupulously tidy household became a symbol of piety and obedience to God. Slovenliness, on the other hand, was seen as a sign of sinfulness and moral decay.
"Cleanliness is next to Godliness" – this famous proverb first emerged in 17th century Puritan writings, crystallizing the deep-rooted belief that a clean home reflects a clean soul.

The Rise of the Domestic Goddess
As the modern era dawned, the ideals of domestic purity only intensified. The 19th century saw the emergence of the "domestic goddess" archetype – the virtuous, selfless woman whose sole purpose was to maintain an impeccable household and ensure the moral upbringing of her family. Books like Catharine Beecher's pioneering A Treatise on Domestic Economy became bestsellers, offering detailed instructions on everything from how to properly clean a fireplace to the importance of airing out bedding.



The Psychological Toll of Domestic Perfection
While the quest for a spotless home may have started as a lofty spiritual pursuit, it has evolved into a modern psychological affliction. Today, the pressure to maintain an impeccable living space has taken a devastating toll, contributing to everything from crippling anxiety and depression to physical health issues.
Studies have shown that people who place an unusually high value on household cleanliness and organization tend to experience heightened levels of stress, dissatisfaction, and even feelings of shame or worthlessness when they inevitably fall short of their own impossibly high standards. This can lead to obsessive-compulsive behaviors, social isolation, and a profound sense of personal failure.
"I feel like I'm constantly failing because I can never get my house as clean as I want it to be. I scrub for hours, but it's never good enough." – Samantha, 36
The Myth of the Immaculate Home
Perhaps most troubling of all is the realization that the entire concept of the "perfect" home is largely a fabrication – a social construct that bears little resemblance to the reality of how most people actually live. Even the most seemingly spotless homes have their own unseen clutter, dust, and disarray lurking just out of sight.
In the age of social media, this disconnect has become even more pronounced, as people curate highly idealized versions of their homes for public consumption. The pressure to present an image of domestic bliss can lead to a vicious cycle of shame, deception, and unrealistic expectations that negatively impact mental health and interpersonal relationships.

Reclaiming Domestic Harmony
Ultimately, the key to domestic well-being may lie in rejecting the notion of perfection altogether. By embracing a more realistic, compassionate attitude toward household management – one that acknowledges the inherent messiness of life – individuals can free themselves from the tyranny of the immaculate home and rediscover the true joy and purpose of domestic spaces.
This shift in mindset not only benefits mental health, but can also have positive ripple effects on family dynamics, community engagement, and even environmental sustainability. After all, a home doesn't need to be spotless to be a haven of comfort, creativity, and connection.
Comments